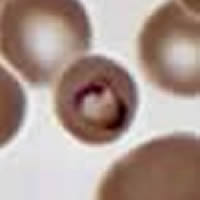
Case 12 Image A

|
|
[Last Modified: ] |
Case
11
An
adult man, an immigrant from El Salvador, went to the Emergency Room of
a U.S. hospital with fever and confusion that did not respond to antibiotic
treatment. A CT scan showed a brain lesion. The patient was
HIV-positive and his last visit to El Salvador was one year earlier. A
spinal tap showed low glucose and high protein levels in the CSF. In
addition, the organisms shown in Figures A through D were
found in the CSF (size approximately 20 micrometers; Giemsa stain). What
is your diagnosis? Based on what criteria? What other diagnostic
tests would you suggest?
 |
 |
| A | B |
 |
 |
| C | D |
Click here for the answer to Case 11.
Case
12
An adult male patient went to a hospital in Virginia with symptoms suggestive
of a complicated course of pneumonia, for which he was treated with antibiotics.
He had traveled to Kenya four months earlier and to Beijing, China six
days earlier. The blood smear showed the organisms seen in Figures
A through D. Note: The infected erythrocyte
in Figure B is not enlarged, compared to noninfected erythrocytes.
What is your diagnosis? Based on what criteria?
|
 |
| A | B |
 |
 |
| C | D |
Click here for the answer to Case 12.
|
|||